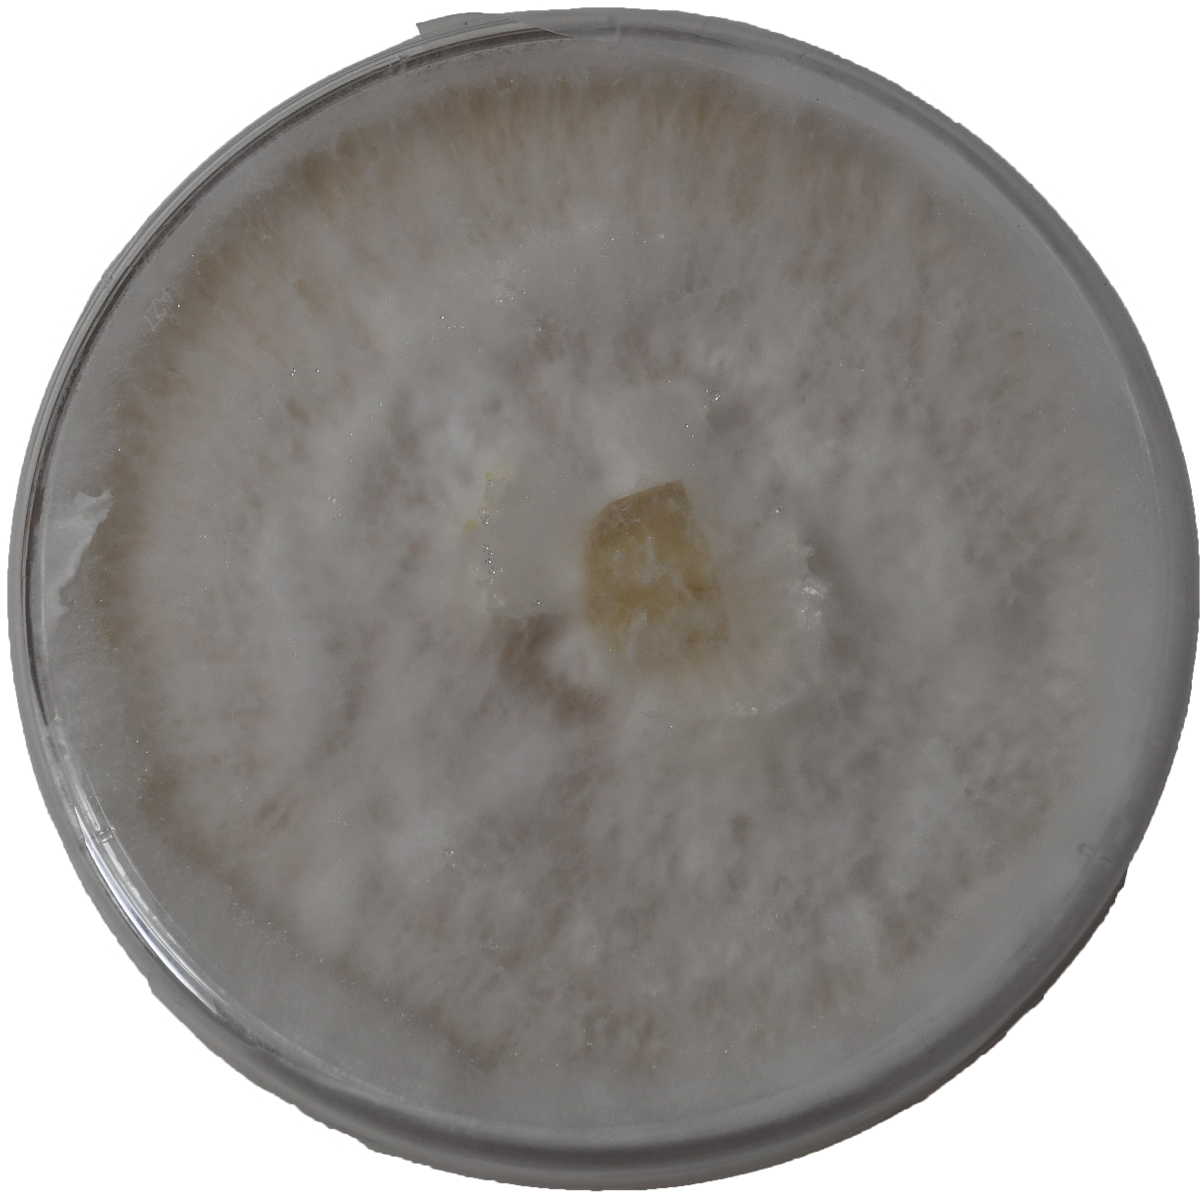
Agar Plate L-Z

Description
- Please note that Colonized Agar Plate will ship separately and it will take 2 weeks to prepare and ship. Order now and let Out Grow help you get your mushroom project started off on the right foot with our Colonized Agar Plate!
This sale is for a single 100mm X 15mm fully colonized agar plate made with MEA agar. The culture we use is directly from our mother slants to ensure a young healthy culture. Your fully colonized agar will come vacuumed sealed with storage instructions. A fully colonized agar plate can be expanded many times, many different ways. We encourage you to do your research to decide which method best suits you.
Please note that Colonized Agar Plate will ship separately and it will take 2 weeks to prepare and ship. Order now and let Out Grow help you get your mushroom project started off on the right foot with our Colonized Agar Plate!
Description
- Please note that Colonized Agar Plate will ship separately and it will take 2 weeks to prepare and ship. Order now and let Out Grow help you get your mushroom project started off on the right foot with our Colonized Agar Plate!
This sale is for a single 100mm X 15mm fully colonized agar plate made with MEA agar. The culture we use is directly from our mother slants to ensure a young healthy culture. Your fully colonized agar will come vacuumed sealed with storage instructions. A fully colonized agar plate can be expanded many times, many different ways. We encourage you to do your research to decide which method best suits you.
Please note that Colonized Agar Plate will ship separately and it will take 2 weeks to prepare and ship. Order now and let Out Grow help you get your mushroom project started off on the right foot with our Colonized Agar Plate!